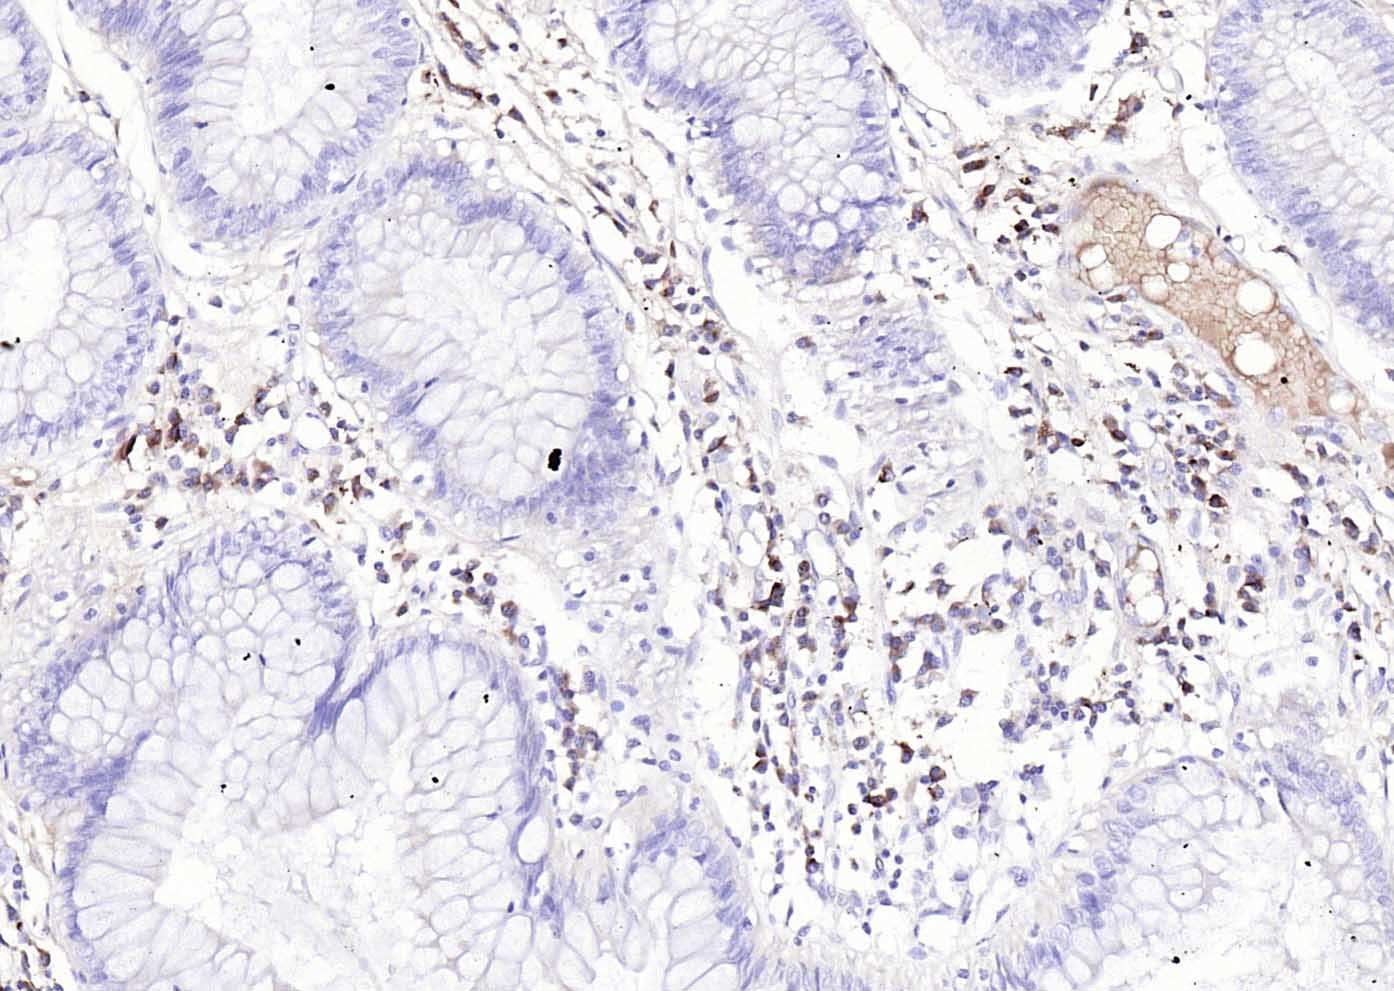
兔抗人IgG-Fc段抗体

human IgG Fc (二抗) | Bioss

货号:bs-0365R
产品详情
相关标记
相关产品
相关文献
常见问题
概述
产品编号
bs-0365R
英文名称
human IgG Fc
中文名称
兔抗人IgG-Fc段抗体
英文别名
Immunoglobulin G Fc fragment; human IgG-Fc; human IgG Fc fragment.
抗体来源
Rabbit
免疫原
human IgG-Fc purified from human plasma.
亚型
IgG
性状
Liquid
纯化方法
affinity purified by Protein A
克隆类型
Polyclonal
浓度
1mg/ml
储存液
0.01M PBS (pH7.4).
研究领域
保存条件
Shipped at 4℃. Store at -20℃ for one year. Avoid repeated freeze/thaw cycles.
注意事项
This product as supplied is intended for research use only, not for use in human, therapeutic or diagnostic applications.
背景资料
The Fc region is the constant region on an immunoglobulin molecule, the area that is exactly the same on all antibodies. The Fc region is found on the heavy chains and is not involved in binding antigens.

产品应用
产品应用: Isotype Control, Blocking Assay, etc., Conjugate-Dependent.
交叉反应
交叉反应: Human
相关产品
暂无相关产品
同靶标产品
相关文献
具体参考文献:bs-0365R 被引用于1文献中